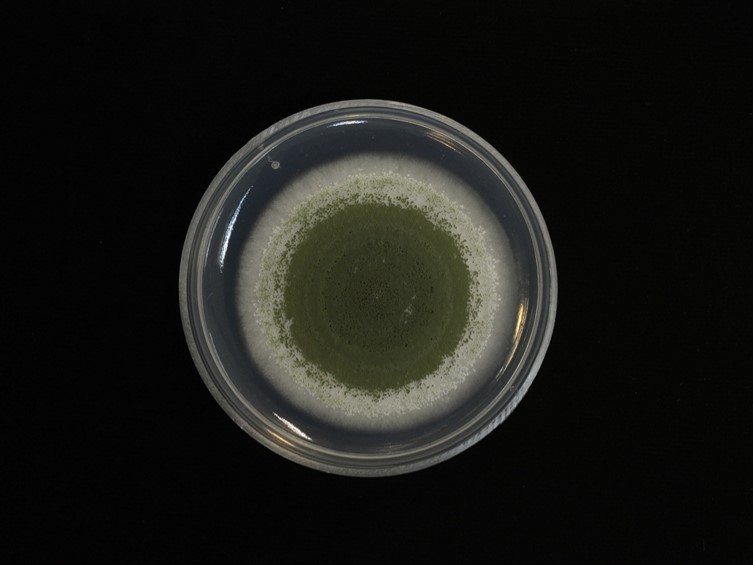

Holotype:
THAILAND, Nakhon Ratchasima Province, Khao Yai National Park, 1 Nov. 2016, B. Sakolrak, D. Thanakitpipattana, N. Arnamnart, N. Kobmoo, R. Somnuk, holotype BBH 44436, ex-type living culture BCC 82988.
Habitat:
In leaf litter.
Host:
Adult cricket (Gryllidae).
Description:
The  host body is covered with greyish green, pastel green and dark green conidia.
host body is covered with greyish green, pastel green and dark green conidia.
Culture characteristics:
Colony on PDA fast-growing, attaining 4.7 cm diam after 14 d at 25 °C, at first white with smooth and cottony mycelia. Conidiation starts in the middle of colony at 5 d, becoming lime green, buff yellow and olive green with age.
Colony on PDA fast-growing, attaining 4.7 cm diam after 14 d at 25 °C, at first white with smooth and cottony mycelia. Conidiation starts in the middle of colony at 5 d, becoming lime green, buff yellow and olive green with age.  Conidiophores arising from aerial mycelium, smooth, cylindrical.
Conidiophores arising from aerial mycelium, smooth, cylindrical.  Phialides smooth-walled, cylindrical to clavate, without a distinct neck, 5–12 × 2–3 μm.
Phialides smooth-walled, cylindrical to clavate, without a distinct neck, 5–12 × 2–3 μm.  Conidia smooth-walled, cylindrical, ovoid, 5–7 × 2–3 μm.
Conidia smooth-walled, cylindrical, ovoid, 5–7 × 2–3 μm.
Reference:
Thanakitpipattana D, Tasanathai K, Mongkolsamrit S, et al. (2020). Fungal pathogens occurring on Orthopterida in Thailand. Persoonia-Molecular Phylogeny and Evolution of Fungi 44: 140–160.
DOI: https://doi.org/10.3767/persoonia.2020.44.06Species |
Strain |
Compound |
Pubchem CID |
Biological activity |
Reference |
|---|
|
Strain |
LSU | RPB1 | RPB2 | SSU | TEF1 |
|---|---|---|---|---|---|
| BCC 22353 | MK632090 | MK632165 | MK632142 | MK632116 | MK632061 |
| BCC 53857 | MK632092 | MK632167 | MK632144 | MK632118 | MK632063 |
| BCC 82988 | MK632091 | MK632166 | MK632143 | MK632117 | MK632062 |